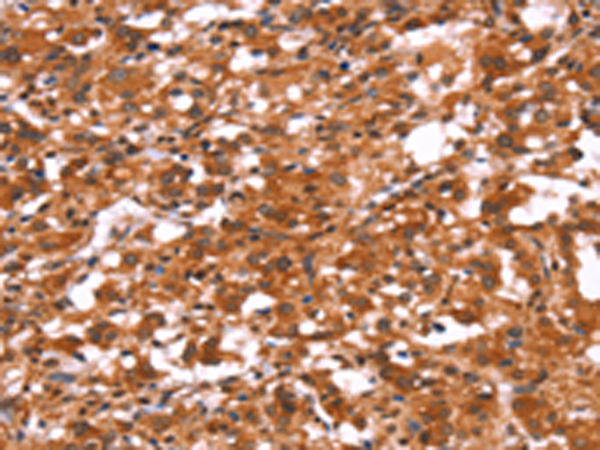

|
Background: |
This gene encodes a gamma-aminobutyric acid (GABA) receptor. GABA is the major inhibitory neurotransmitter in the mammalian brain where it acts at GABA-A receptors, which are ligand-gated chloride channels. Chloride conductance of these channels can be modulated by agents such as benzodiazepines that bind to the GABA-A receptor. GABA-A receptors are pentameric, consisting of proteins from several subunit classes: alpha, beta, gamma, delta and rho. Mutations in this gene cause juvenile myoclonic epilepsy and childhood absence epilepsy type 4. Multiple transcript variants encoding the same protein have been identified for this gene |
|
Applications: |
ELISA, WB, IHC |
|
Name of antibody: |
GABRA1 |
|
Immunogen: |
Synthetic peptide of human GABRA1 |
|
Full name: |
gamma-aminobutyric acid (GABA) A receptor, alpha 1 |
|
Synonyms: |
EJM; ECA4; EJM5 |
|
SwissProt: |
P14867 |
|
ELISA Recommended dilution: |
2000-5000 |
|
IHC positive control: |
Human thyroid cancer and Human gastric cancer |
|
IHC Recommend dilution: |
25-100 |
|
WB Predicted band size: |
52 kDa |
|
WB Positive control: |
LoVo cells |
|
WB Recommended dilution: |
500-2000 |

購物車
幫助
021-54845833/15800441009
